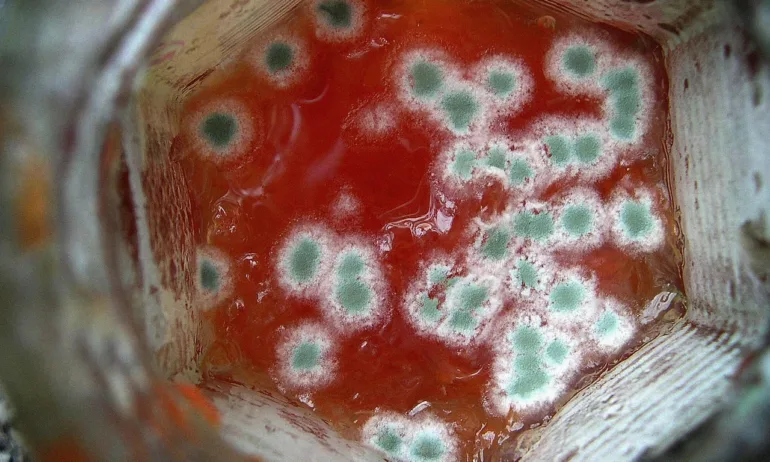
Затвориха хотел в Турция заради разследване за отравяне с храна, причинило смъртта на жена и двете ѝ деца - Tribune.bg

Затвориха хотел в Турция заради разследване за отравяне с храна, причинило смъртта на жена и двете ѝ деца
Снимката е описателна
Затвориха хотел в Турция заради разследване за отравяне с храна, причинило смъртта на жена и двете ѝ деца, съобщава ТРТ Хабер.
По информация на Главната прокуратура на Истанбул разследването е свързано с турско семейство, което пристигнало на почивка от Германия на 9 ноември. На третия ден от престоя им родителите и двете им деца били приети в болница със симптоми на хранително натравяне. Заедно с тях постъпили и двама други посетители от хотела, в който семейството било отседнало.
Въпреки усилията на лекарите, майката и двете деца починали малко след като били приети в лечебното заведение. Към момента продължават усилията за стабилизирането на бащата, чието състояние остава усложнено.
По данни на полицията са задържани служители на хотела и на фирма, която пръскала обекта срещу насекоми непосредствено преди инцидента. Разследването по случая продължава, като към момента се изчакват резултати от изследвания на храната в хотела, които биха могли да дадат яснота относно случилото се.
FaceBook Twitter Pinterest https://tribune.bg/bg/svqt/zatvoriha-hotel-v-turtsiya-zar/









